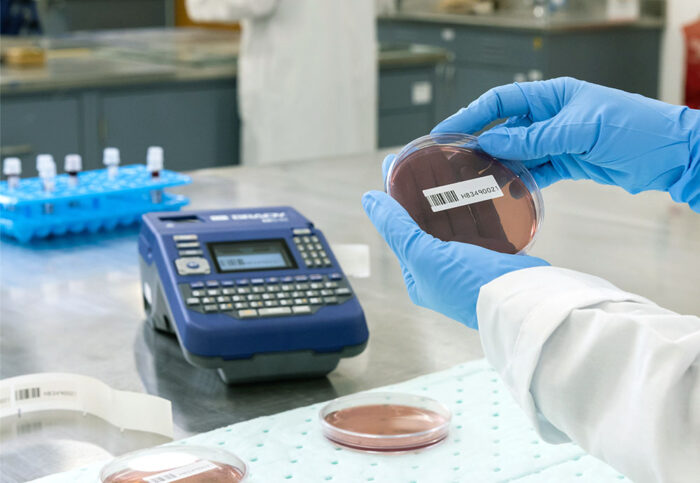
LABORATORY

ラベルプリンター M510
キーボード搭載タイプのラベルプリンター
QWERTYキーボード、テンキー、カラー液晶ディスプレイを搭載
研究室、作業現場など場所を問わずQWERTYキーパッドを使用して最大1.5インチ幅のラベルをオンデマンドでデザイン・印刷できます。またBrady Workstationソフトウェア(別売)を使用してオフィスでラベルの作成も可能です。キーパッド、液晶ディスプレイ搭載プリンター。

オーセンティックカートリッジを使用しているので、セットしたラベルの種類や適切な印字濃度設定をカートリッジ式リボンで自動認識します。スムーズにセットアップします。
PCからの操作もできるポータブルプリンター
|
PCからはBrady Workstation(別売)を使用してラベルの作成ができます。
|
 |
コンパクトで持ち運べ、プリンターから直接ラベルを作成
|
プリンター本体のキーボードを使用して、手軽にラベルの作成ができます。
|
 |
動画
M510プリンター概要 |
仕様
| プリンター機種名 | M510 | |
|---|---|---|
| 印字方式 | 熱転写式 | |
| 解像度 | 300dpi | |
| 印字速度 | 38.1mm/秒 | |
| 印字可能サイズ | 幅:38.1mm | |
| 対応ラベル幅 | 38.1mm | |
| パソコン接続 | PC接続(USB)、スタンドアローン | |
| インターフェイス | USB | |
| ソフトウェア対応 | CODESOFT(コードソフト) Brady Workstation(ブレイディワークステーション) |
|
| 電源 | ACアダプター、リチャージャブルバッテリー | |
| バッテリータイプ | ニッケル水素バッテリー(1,200mAh) | |
| 外形寸法(幅×奥行×高さ) | 約 147 × 260 × 93 mm | |
| 重量 | 約 1.5 kg(電池パック含む) | |
| ディスプレイ | カラーディスプレイ(2.8in) | |
| キーボード | QWERTYキーボード | |
| メモリー | 512MB RAM , 256MB Flash | |
| フォントサイズ | 4~170ポイント | |
| シリアライズ(連番) | 可 | |
| バーコード(一次元) |
スタンドアローン時 ラベルデザインソフトウェア使用時 CODESOFT(コードソフト) |
|
| バーコード(二次元) |
スタンドアローン時 ラベルデザインソフトウェア使用時 CODESOFT(コードソフト) |
|
| 印字プレビュー機能 | あり | |
| 搭載シンボル(記号) | 480 | |
| 付属品 | ニッケル水素バッテリーパック、ACアダプター、USB接続ケーブル、M5C-1500-595-WT-BK、USBドライブ(ユーザーマニュアル、クイックスタートガイド、Windowsドライバー) | |
| ラベル・リボンサプライ品 | M511/M510/BMP51/BMP41プリンター用カートリッジラベルサイズ表 | |
| 主なラベル基材 |
B-342 絶縁性・耐溶剤性 |
|
| プリンタードライバー | Windows11 、Windows10(64bit)、 | |
| マニュアル | サポート・M510サポート情報をご参照ください。 | |
| 保証期間 | 購入時から6ヶ月間 以降の保守については、サポートページ・ラベルプリンターサポートをご覧ください。 |
|
| 備考 | オートカッター機能搭載、1.2m高の落下耐性 | |
 BradyオーセンティックカートリッジはM510プリンターとシームレスに連動し、パフォーマンスと信頼性を向上させます。M510プリンターは、オーセンティックマークの無いカートリッジ(Brady製でないもの、または旧世代のBradyプリンターのカートリッジ)とは互換性がありません。詳細はこちら
BradyオーセンティックカートリッジはM510プリンターとシームレスに連動し、パフォーマンスと信頼性を向上させます。M510プリンターは、オーセンティックマークの無いカートリッジ(Brady製でないもの、または旧世代のBradyプリンターのカートリッジ)とは互換性がありません。詳細はこちら
ご注意
1. 仕様は予告なしで変更する場合があります。予めご了承ください。
2. 全ての製品に関して、ご購入の際は、実際に製品を使用した環境適応テストの実施をお勧めします。
- 産業用プリンタ
- ポータブルプリンタ
- バーコードリーダー
- 自動貼付け機
お問い合わせ
お問い合わせフォームをご利用の前に、当社のプライバシーポリシー及びクッキー使用についてを必ずご参照ください。このお問い合わせフォームは、SSLに対応しております。
フォームが表示されるまでしばらくお待ち下さい。
恐れ入りますが、しばらくお待ちいただいてもフォームが表示されない場合は、こちらまでお問い合わせください。